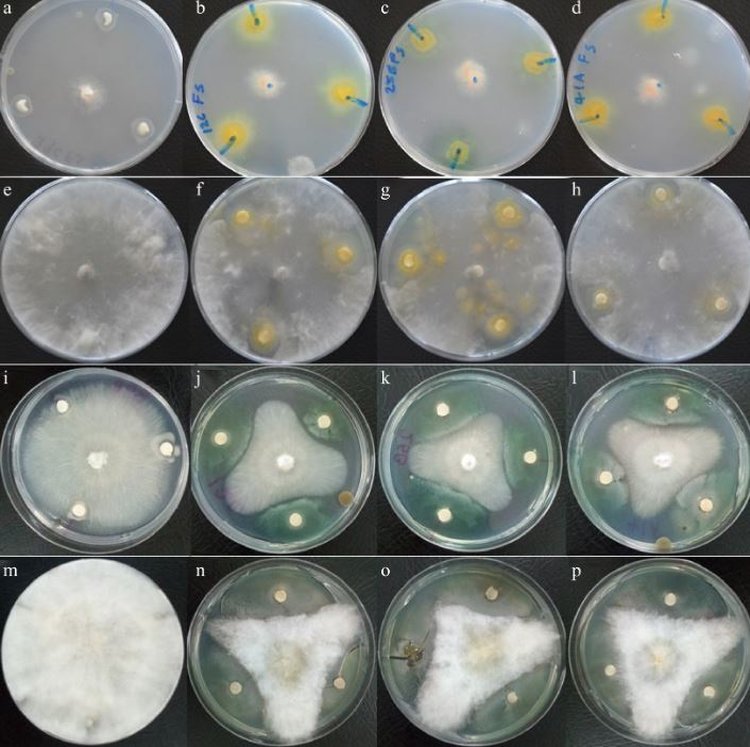

В Танзании ученые Факультета естественных наук и биоинженерии (LiSBE), Африканский институт науки и технологий имени Нельсона Манделы, - Моника Д. Накей, Павитравани Б. Венкатарамана и Патрик А. Ндакидеми – оценили штаммы Rhizobium и Bradyrhizobium как потенциальных агентов биологической борьбы с грибами корневой гнили сои.
Ризобии широко известны своей способностью фиксировать азот в симбиотической ассоциации с растениями, особенно бобовыми, к которым относится соя. Фиксация азота происходит симбиотически посредством образования корневых клубеньков в бобовых растениях, где фиксированный азот преобразуется в аммиак для усвоения растениями-хозяевами. Это естественный процесс, который снижает потребность и использование синтетических удобрений, что приводит к снижению затрат на производство
Помимо своей хорошо известной способности фиксировать азот, ризобии обладают эффективностью в подавлении почвенных патогенов, которые поражают растения. Следует отметить, что в поле соя может быть заражена более чем одним патогеном, что усугубляет ситуацию.
Исследователи из Африканского института науки и технологий имени Нельсона Манделы сосредоточились на инокуляции семян сои ризобиями против 4 распространенных почвенных патогенов: ризоктониоз сои (Rhizoctonia solani), фузариум остроспоровый (Fusarium oxyporum) и фузариум пасленовый (Fusarium solani), а также угольная склероциальная гниль сои (Macrophomina phaseolina).
«Перечисленные грибные патогены - Rhizoctonia solani, Fusarium oxyporum и Fusarium solani - были выделены из корней зараженных растений сои во время вегетационного периода, а Macrophomina phaseolina была выделена из зараженных семян сои. Идентификация и отбор проб зараженных растений сои проводились на фермерских полях в городском совете Мбеи. Растения отбирались на основе видимых симптомов на побегах растений. Во время отбора проб наблюдались специфические симптомы, такие как пораженные листья при заражении Rhizoctonia solani, задержка роста, пожелтение и гибель старых растений в присутствии Fusarium solani и Fusarium oxyporum, а также преждевременная гибель с прикрепленными листьями и серым налетом на нижнем стебле и стержневом корне для Microphomina phaseolina. Отбор проб производился на стадиях рассады, цветения и зрелости до высыхания растений. Симптомы поражения Microphomina phaseolina чаще всего проявляются в период созревания, болезнь распространяется на семена. Ингибирование корневых грибов было протестировано путем выращивания штаммов ризобий и 5-миллиметровых дисков грибов на агаре Чапека-Докса. Каждый тест был в трех повторностях, и чашки Петри инкубировались при 28 °C в течение 7 дней. Расстояние между колонией грибов и диском считалось зоной ингибирования, которая измерялась в мм для получения среднего значения для трех повторностей», - рассказывают исследователи.
Из 25 проверенных штаммов ризобий только три из них, Rhizobium sp. TZSR12C, TZSR25B и Bradyrhizobium sp. TZSR41A, были способны подавлять рост указанных четырех грибных патогенов в условиях in vitro .
Кроме того, режимы подавления включали образование или отсутствие образования зоны ингибирования в зависимости от изолята гриба. Наибольший диаметр (8,3 мм) зоны ингибирования был образован Rhizobium sp. TZSR25B против F. oxyporum, за которым следует (5,7 мм) у Bradyrhizobium sp . TZSR41A, при этом наименьшая (1,3 мм) была у Rhizobium sp . TZSR12C против M. phaseolina.
Ингибирование роста грибов бесклеточными культуральными фильтратами штаммов ризобий в агаровом диско-диффузионном анализе. Источник: Technology in Agronomy (2024). DOI: 10.48130/tia-0024-0007.
TZSR12C был способен образовывать чистые зоны у трех грибов, F. solani, M. phaseolina и R. solani, в то время как Rhizobium sp. TZSR25B и Bardyrhizobium sp. TZSR41A были способны образовывать зоны ингибирования только у двух грибов, которыми являются F. solani и M. phaseolina. С другой стороны, самая большая колония 25,0 мм против F. oxyporum и сразу за ней 25 мм против R. solani, в то время как самая маленькая колония 4,7 мм против M. phaseolina были образованы Rhizobum sp. TZSR25B.
Штаммы ризобий в этом исследовании, как было отмечено, улучшают прорастание семян сои в почвах, инокулированных единственными или комбинацией различных грибных патогенов. Способность ризобий улучшать прорастание бобовых, включая сою, была продемонстрирована в различных исследованиях. В этом исследовании штамм Rhizobium sp. TZSR12C улучшил прорастание до 93,33% в почвах, инокулированных F. solani, R. solani и M. phaseolina.
В заключение, исследователи отмечают, что процент улучшения прорастания семян штаммами ризобий в этом исследовании заметно выше, чем 83,3%, полученные в предыдущих исследованиях , что свидетельствует о более высокой эффективности протестированных видов ризобий в воздействии на прорастание семян.
По статье группы авторов (Моника Д. Накей, Павитравани Б. Венкатарамана, Патрик А. Ндакидеми), опубликованной в журнале Technology in Agronomy.
На заглавном фото вы видите симптомы гнилей сои, наблюдаемые на (а) рассаде, (б) цветущих и (в) зрелых растениях. Фото принадлежит группе указанных авторов.
